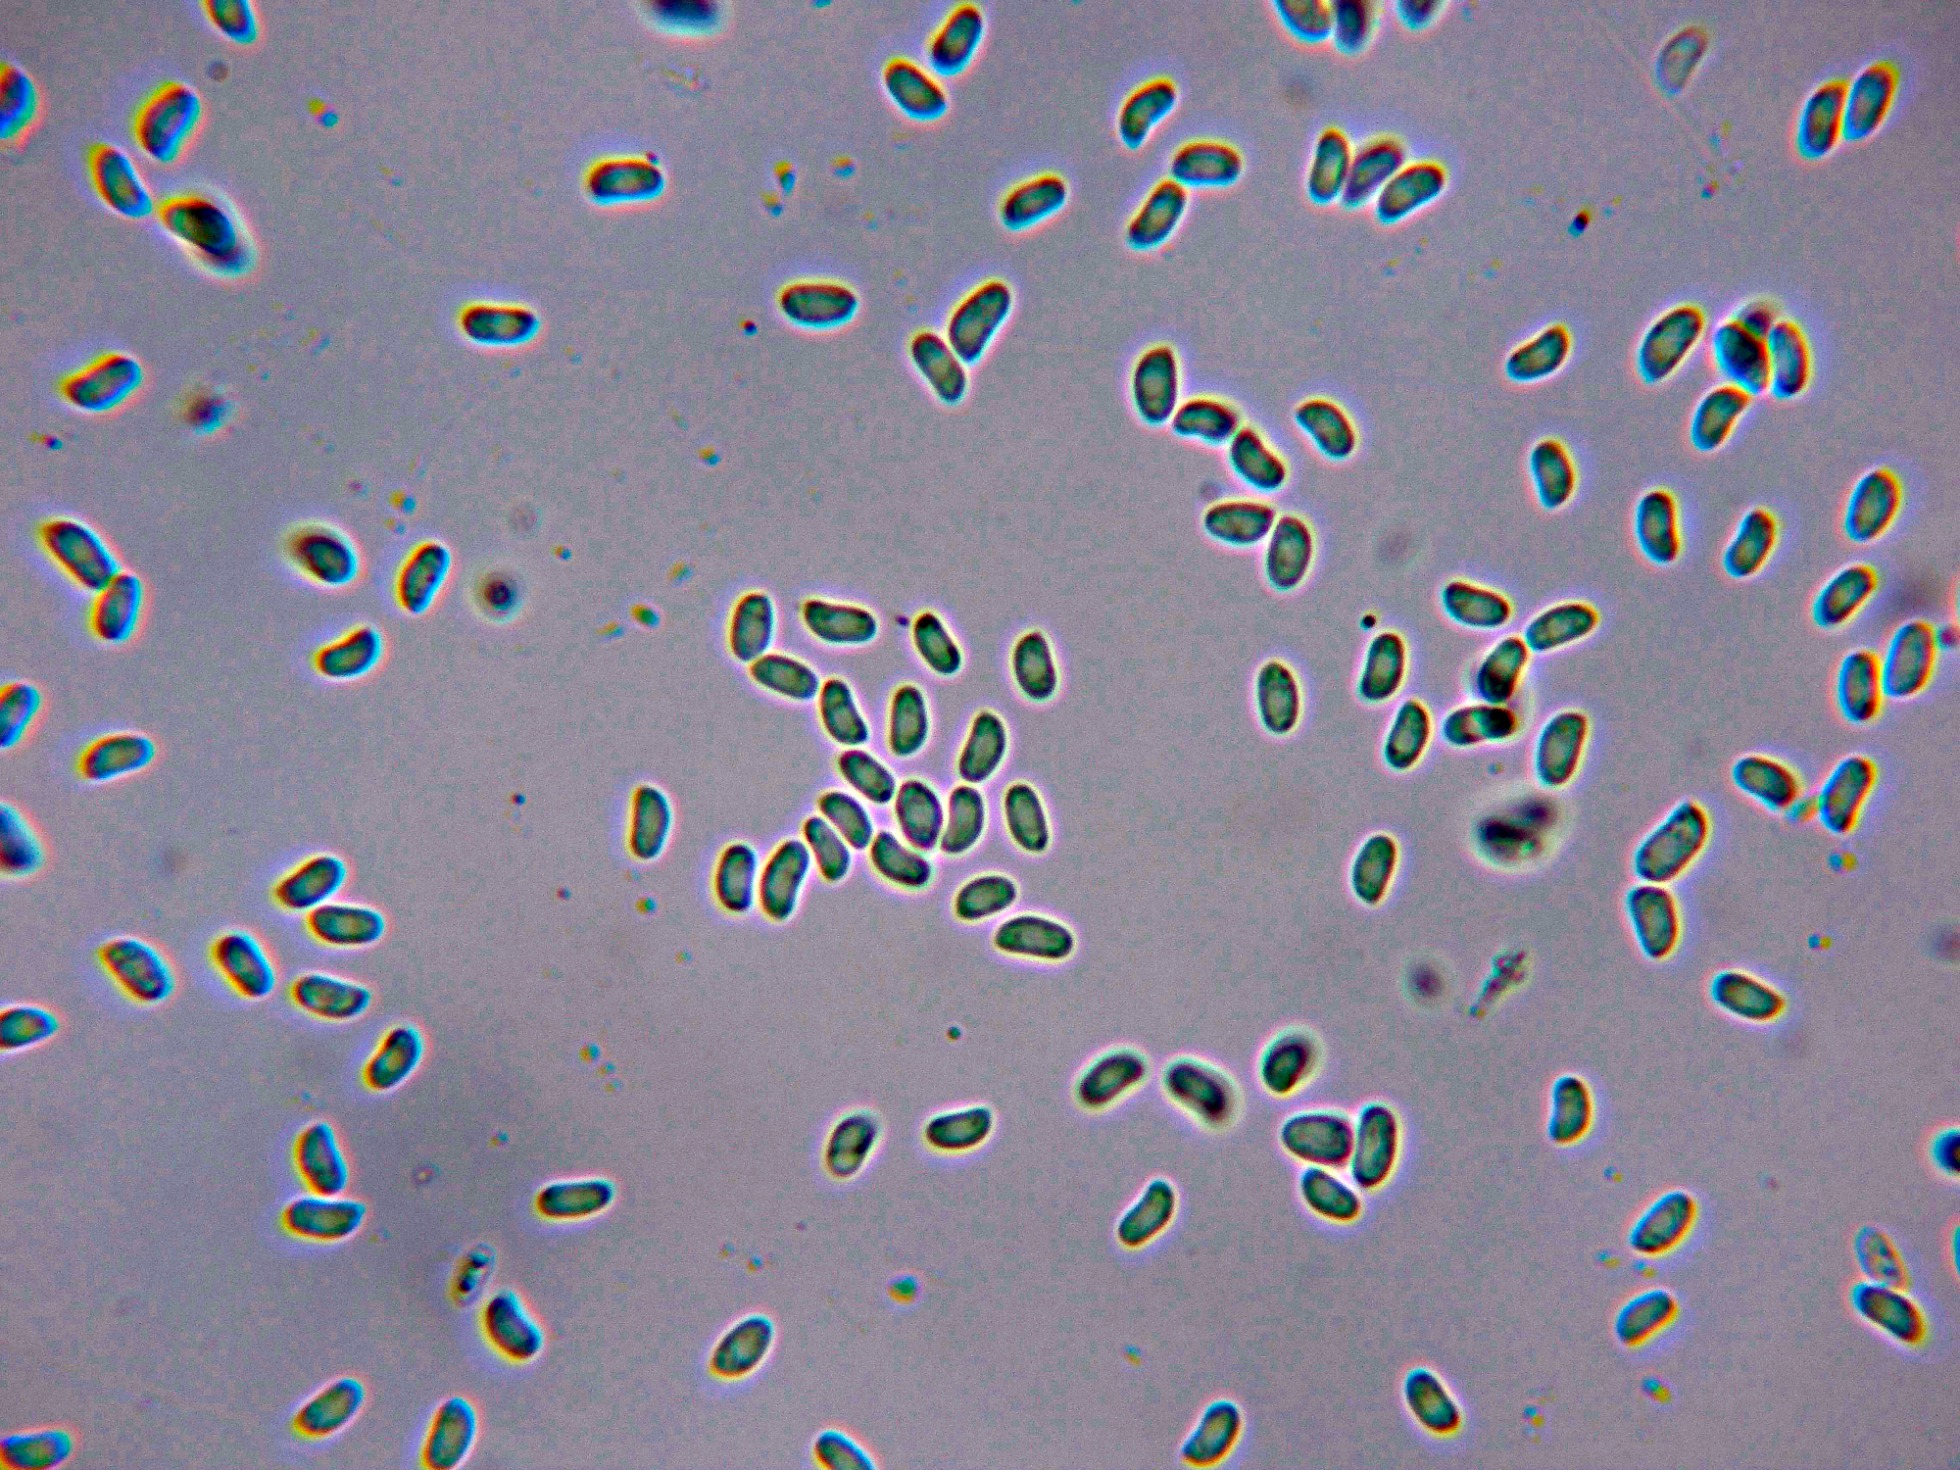

- Foro
- Foros sobre Micología de fungipedia
- Microscopía
- Efibulella deflectens (P. Karst.) Zmitr. Microscopía.
 Efibulella deflectens (P. Karst.) Zmitr. Microscopía.
Efibulella deflectens (P. Karst.) Zmitr. Microscopía.
- Josep Torres
-
 Autor del tema
Autor del tema
- Fuera de línea
- Moderador
-

Menos
Más
- Mensajes: 8746
- Gracias recibidas: 8379
2 años 10 meses antes #108857
por Josep Torres
Hola a tod@s.
Un Cortical del pasado domingo sobre la superficie de un tronco en una zona donde predominaban las encinas.
Efibulella deflectens (P. Karst.) Zmitr
Syn: Phlebia deflectens
De consistencia cérea y poco grosor, a 20 aumentos se observa una superficie algo granulosa, aunque no se corresponde a la especie sino a las irregularidades del tronco huésped, ya que de grosor no llega ni de lejos al medio milímetro.
Sistema hifal monomítico, con hifas subiculares con septos simples, desprovistas de fíbulas.
Una de las características de la Efibulella deflectens son sus cistidios cilíndricos, con gutulaciones en su interior, en este estudio con unas medidas de (36.8) 42.9 - 49.3 (61.1) × (4.1) 4.4 - 5.7 (5.8) µm.
Los basidios.
Sección de los basidios cilíndricos y alargados de hasta 45 micras, sin fíbulas en su base.
Las esporas en Reactivo de Melzer, inamiloides.
Las esporas obtenidas por esporulación natural y en agua.
Estas esporas con unas medidas de:
(4.6) 4.65 - 5.3 (5.5) × (2.2) 2.3 - 2.8 (3.1) µm
Q = (1.7) 1.8 - 2.2 (2.3) ; N = 40
Me = 5 × 2.5 µm ; Qe = 2
Observaciones: Determinación hecha siguiendo el criterio de "Les Champignons de Suisse" Tomo 2 Nº 173, donde se indican para la Phlebia deflectens = Efibulella deflectens unas medidas de los cistidios de 45-60 x 4,5-6 µm. unos basidios de hasta 45 µm. y unas medidas esporales de 4-5,5 x 2,3-3 um,, parámetros totalmente acordes a los de este estudio.
Añado un pantallazo de la misma fuente con la microscopía.
Saludos a tod@s.
Un Cortical del pasado domingo sobre la superficie de un tronco en una zona donde predominaban las encinas.
Efibulella deflectens (P. Karst.) Zmitr
Syn: Phlebia deflectens
De consistencia cérea y poco grosor, a 20 aumentos se observa una superficie algo granulosa, aunque no se corresponde a la especie sino a las irregularidades del tronco huésped, ya que de grosor no llega ni de lejos al medio milímetro.
Sistema hifal monomítico, con hifas subiculares con septos simples, desprovistas de fíbulas.
Una de las características de la Efibulella deflectens son sus cistidios cilíndricos, con gutulaciones en su interior, en este estudio con unas medidas de (36.8) 42.9 - 49.3 (61.1) × (4.1) 4.4 - 5.7 (5.8) µm.
Los basidios.
Sección de los basidios cilíndricos y alargados de hasta 45 micras, sin fíbulas en su base.
Las esporas en Reactivo de Melzer, inamiloides.
Las esporas obtenidas por esporulación natural y en agua.
Estas esporas con unas medidas de:
(4.6) 4.65 - 5.3 (5.5) × (2.2) 2.3 - 2.8 (3.1) µm
Q = (1.7) 1.8 - 2.2 (2.3) ; N = 40
Me = 5 × 2.5 µm ; Qe = 2
Observaciones: Determinación hecha siguiendo el criterio de "Les Champignons de Suisse" Tomo 2 Nº 173, donde se indican para la Phlebia deflectens = Efibulella deflectens unas medidas de los cistidios de 45-60 x 4,5-6 µm. unos basidios de hasta 45 µm. y unas medidas esporales de 4-5,5 x 2,3-3 um,, parámetros totalmente acordes a los de este estudio.
Añado un pantallazo de la misma fuente con la microscopía.
Saludos a tod@s.
Adjuntos:
El siguiente usuario dijo gracias: Juan Andrés Román, Juan
Por favor, Identificarse para unirse a la conversación.
- Juan Andrés Román
-

- Fuera de línea
- Spammer
-

Menos
Más
- Mensajes: 2558
- Gracias recibidas: 2756
2 años 10 meses antes #108864
por Juan Andrés Román
Respuesta de Juan Andrés Román sobre el tema Efibulella deflectens (P. Karst.) Zmitr. Microscopía.
Buen aporte Josep.................Saludos
El siguiente usuario dijo gracias: Josep Torres, Juan
Por favor, Identificarse para unirse a la conversación.
- Juan
-

- Fuera de línea
- Moderador
-

Menos
Más
- Mensajes: 553
- Gracias recibidas: 608
2 años 10 meses antes #108905
por Juan
Respuesta de Juan sobre el tema Efibulella deflectens (P. Karst.) Zmitr. Microscopía.
Buen trabajo como siempre Josep 
El siguiente usuario dijo gracias: Josep Torres
Por favor, Identificarse para unirse a la conversación.
- Foro
- Foros sobre Micología de fungipedia
- Microscopía
- Efibulella deflectens (P. Karst.) Zmitr. Microscopía.
Tiempo de carga de la página: 0.048 segundos

Foro de micología